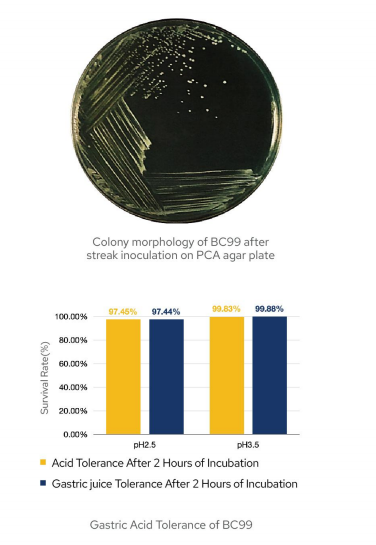
image.png

Strain Identification
BC99 exhibits a typical colony morphology of pale yellow, circular, opaque colonies with a moist surface and regular edges . It is Gram-positive. Microscopic examination shows rod-shaped cells that occur singly or in pairs, with visible spore formation. The cell size measures 0.4–0.6 μm × 1.5–4.0 μm.

Light micrograph (left, ×1600 magnification) and scanning electron micrograph (right, ×20000 magnification) of Weizmannia coagulans BC99.

**Circular Genome Map of Weizmannia coagulans BC99**
Complete genome sequencing of BC99 was performed using the PacBio Sequel II platform. Sequencing results reveal that the BC99 genome comprises a single circular chromosome with a full length of 3,655,496 bp and a GC content of 46.23%. Further genome annotation identified functional domains related to acid tolerance, bile salt resistance, and cell adhesion in this strain.
The complete genome sequence of BC99 has been deposited in the NCBI GenBank database under the accession number CP092692.1. Raw sequencing reads were submitted to the NCBI Sequence Read Archive (SRA) with the SRA accession number SRR11093074. Additionally, the associated BioProject and BioSample accession numbers are PRJNA809837 and SAMN26203093, respectively [3].
Probiotic Properties
Through rigorous experimental determination, BC99 was found to exhibit exceptional stress tolerance. Following incubation in simulated gastric fluid (SGF) and simulated intestinal fluid (SIF) at 37°C for 2 hours, the strain displayed a survival rate of over 90% [4].
Furthermore, BC99 is capable of producing catalase. This enzyme is instrumental in protecting cells from oxidative damage, supporting immune defense, and maintaining skin health.